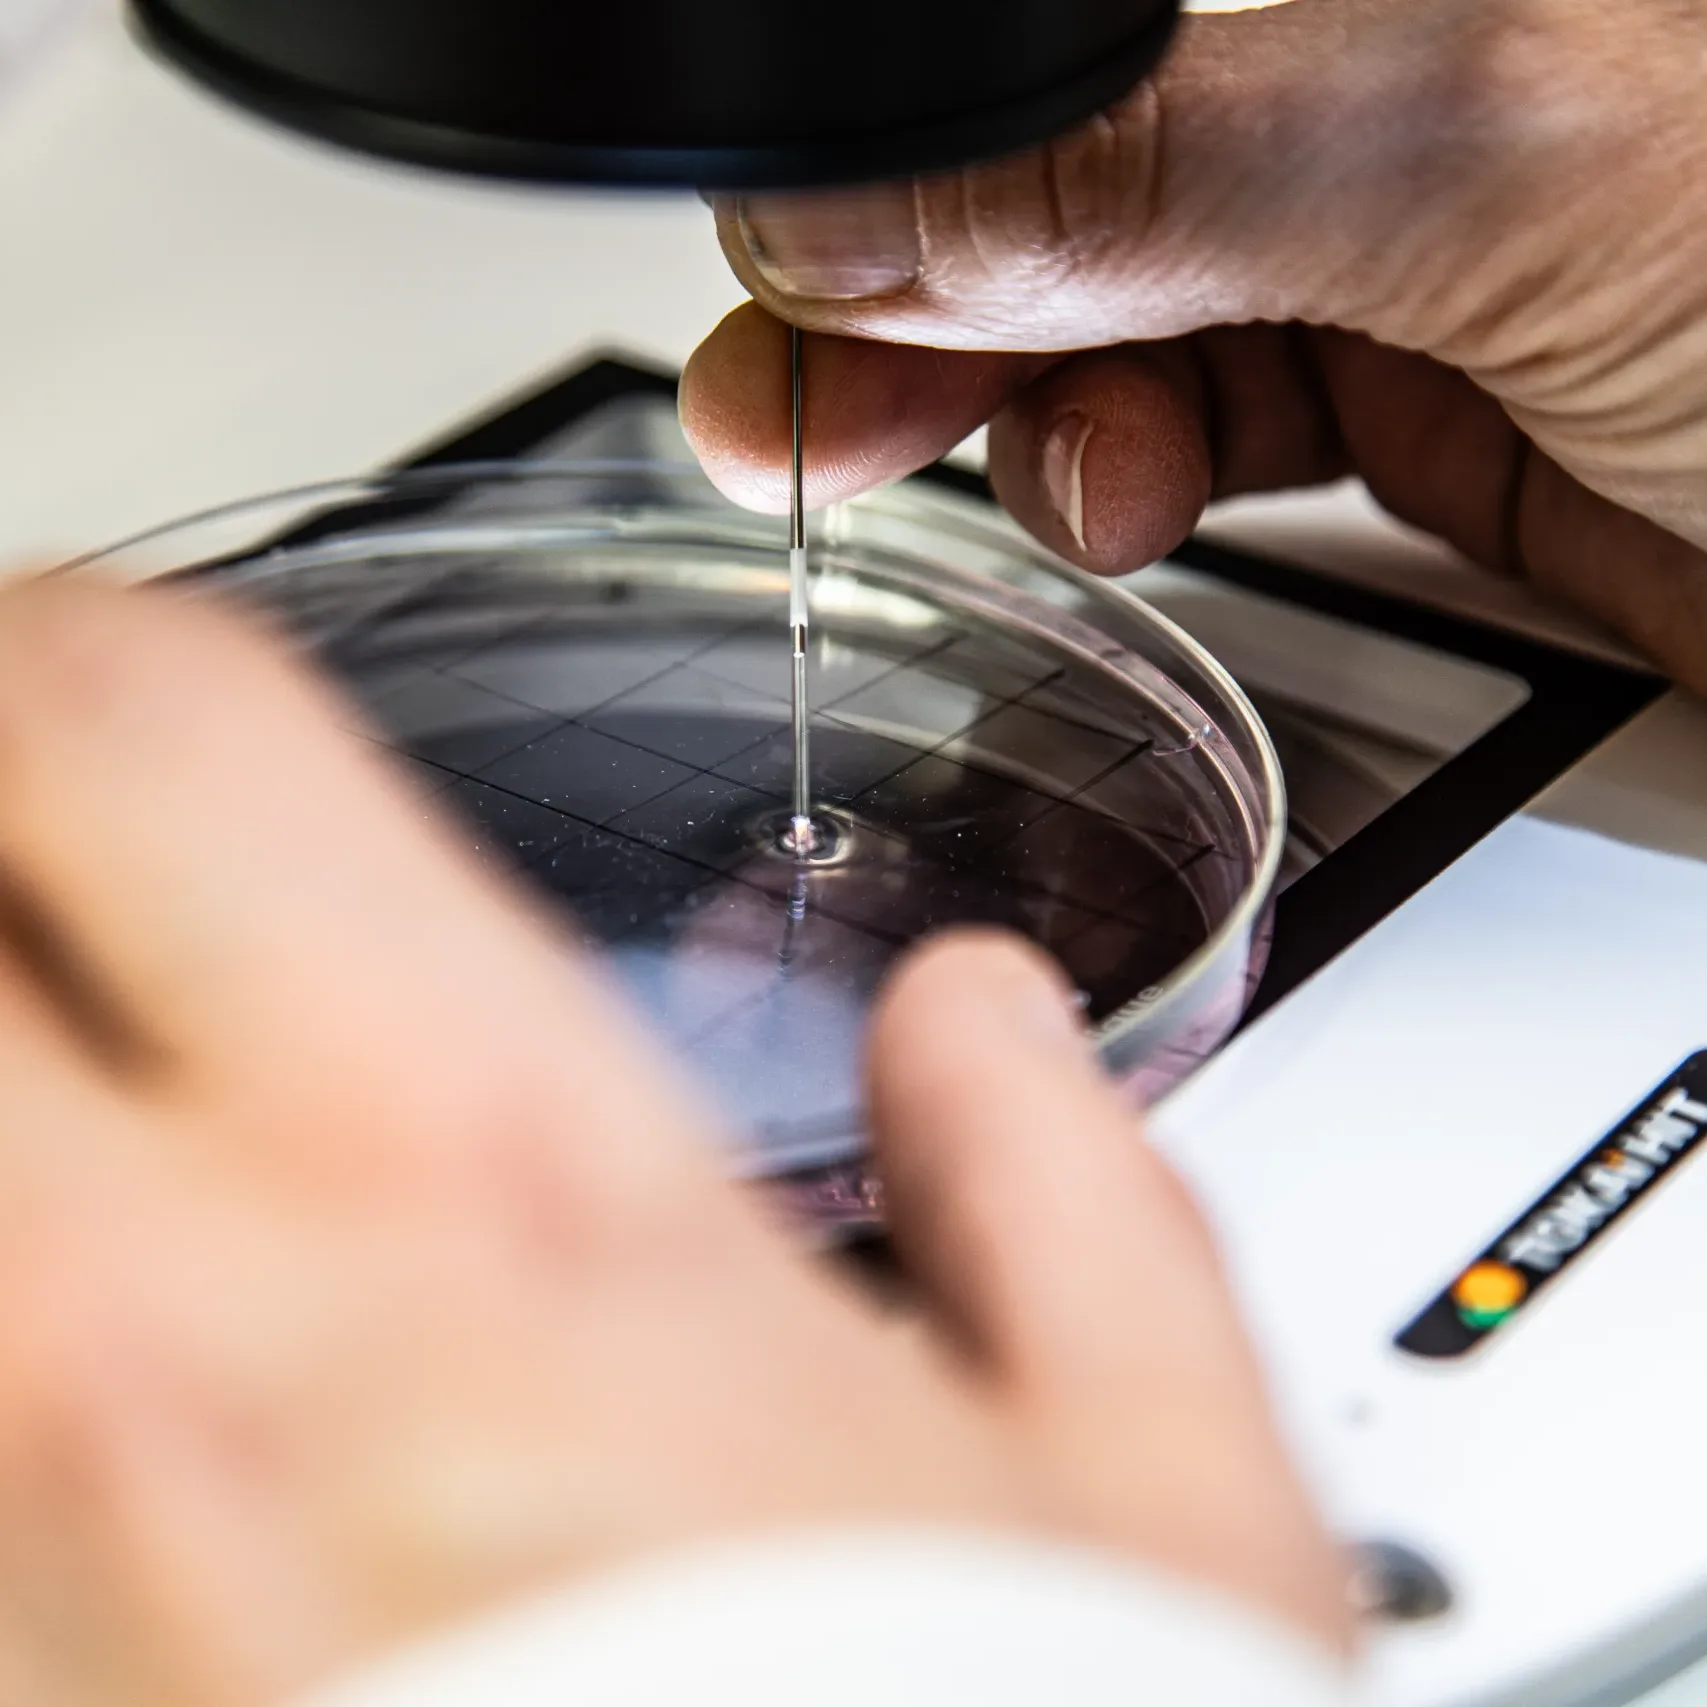

The Guardians Campaign
The Toronto Zoo has a bold new vision - to scale impact for generations to come. It involves transformative investments in infrastructure, experiential learning, animal well-being, and conservation science.
The Guardians Campaign is more than just a fundraising effort—it’s a movement. With a goal of $60 million in philanthropic investment this campaign will enable your Toronto Zoo to:

Be a Guardian of Wild Experiences
Inspire & educate the next generation

Be a Guardian of Wild Life
Elevate animal well-being

Be a Guardian of Wild Futures
Preserve, protect, and restore biodiversity
Current Priorities

Toronto Zoo Community Conservation Centre

Red Panda Habitat
Canada's Wildlife Cryobank
FAQs
Where hope meets action:
As we confront the dual challenges of climate change and biodiversity loss, we are fuelled by a profound sense of optimism, confident in the Zoo’s expertise and ability to drive meaningful, lasting change.
Contact us to learn more:
Kathy Koch, Executive Director
416-392-5913
kkoch@torontozoo.ca
